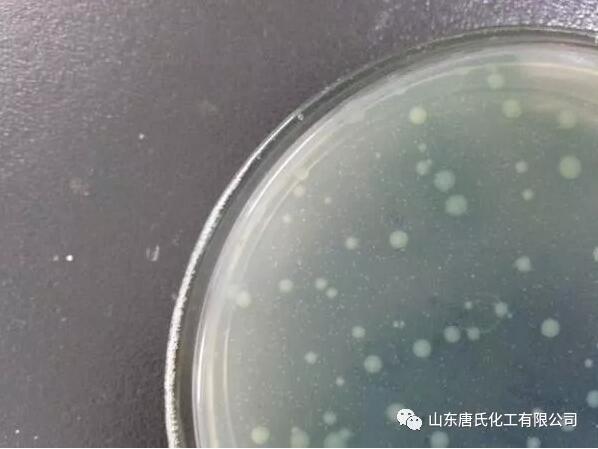

菌肥效果不明显?你可能忽略了这7点!
当前土壤问题日渐突出,菌肥逐渐成了热门的肥料!只是有些人使用菌肥之后却反映效果不明显,或者说压根就看不到效果,这到底到底是什么原因呢?得从下面这7点分析。

01
影响菌肥效果的4个因素
1.土壤理化性质恶化,菌在土壤中不易存活。
(1)土壤中的有机质不足
大家都知道,菌肥中的菌想要在土壤中生存的话,必须依赖于土壤中的有机质。
如果土壤中含的有机质不够,土壤中没有足够的微生物来促使菌肥发酵繁衍形成有效的菌群,即使施了大量的菌肥,菌也没有办法长期存活,也是白搭。
所以,在使用菌肥时可以和有机肥一起使用,保证土壤中有充足的有机质。
但是要注意一点,千万不要和没腐熟的农家肥一起用,因为农家肥在土壤里继续腐熟,产生的热量会烧死有效菌。
(2)土壤板结,含氧量少
因为人们常年的施肥习惯(不施或少施有机肥、浅施无机肥),造成土壤板结,土壤含氧量差等问题。像需氧性很强的菌种比如(放线菌、芽孢类菌、根瘤菌等),施在板结、透气性差的土壤里,不要说让它繁殖发挥作用了,就连存活都很困难。

2.对菌种不了解
很多农民只知道菌肥好,有益菌能够抑制土壤里的有害菌繁殖,预防土传病害、还能促进作物生长,好像菌肥就是万能肥一样。
但其实,不同的菌种发挥的作用是不一样的,每个菌种有自己专门的作用,不了解菌种而胡乱使用,也是起不到相应作用的。
所以我们一定要对菌种的作用有所了解,然后根据使用目的,合理地选择菌肥。
3.菌肥施用的温、湿度不适宜
很多人在使用菌肥时,并不考虑环境影响,只想着菌肥好,能提高作物的抗逆性,只管施就行了,看别人随水冲施,自己也大量冲水,而并不了解菌肥应该处于什么样的环境中。
(1)温度上
在使用菌肥时,一般要求土壤温度控制在5~35℃的范围内。
温度低于5℃的话,菌种不能发酵繁殖,高于35℃的话,菌种可能会被烧死,超过这两个土壤温度界限,菌肥的施用效果都会比较差。

(2)湿度上
土壤含水量一般在50-70%时比较适宜。
像那种固氮菌类菌肥,适宜的土壤湿度应保持在60%左右,也就是见干见湿的土壤湿度最为适宜。
另外,还要注意:随水冲施时,尽量选择可以冲施的菌肥来用,而且尽量不要让菌长时间处于淹水状态,以免影响菌的活性。

4.不合理的混用
现在很多人为了省事会把菌肥跟其他肥料一起混用,但是如果混用不当,就会对菌的活性造成一定影响。
· 菌肥和杀菌剂、杀虫剂、除草剂等混合使用
菌肥和过酸或过碱的肥料一起使用
菌肥与高浓度的化肥混用或菌肥与化肥混用时吸潮,影响了菌的活性等。
这些不合理的混用都会影响菌的存活,从而影响使用效果。

所以在混用时需要注意下边这些禁忌:
(1)菌肥不能和杀菌剂、杀虫剂、除草剂和含硫化肥(如硫酸钾、稻草灰)、过酸或过碱的肥料等混用。使用不当,这些药、肥很容易杀死生物菌。
(2)菌肥与化肥混用时,时间上最好前后分开使用或者是使用时要撒施均匀,若穴施的话,要分隔开,避免长时间紧密接触。
02
想要菌肥很好的发挥效果,还要注意以下3点:
1.在使用时,把握早、近的原则。

(1)施入时间要早,一般做基肥会比较好。苗期施用可以发挥促生长的作用,促进扎根,发芽等。
(2)距离根系要近,在根系周围容易发挥作用。深度要合适,要和根系的深度接近,但不要太深容易没氧。
2.多种生物菌肥不宜同时使用。
在用生物菌肥时,最好只使用一种,不要同时使用含有不同有益菌的多种生物菌肥,也不要经常更换使用不同种类的生物菌。
因为生物菌肥要发挥作用,需要有益微生物大量繁殖才能发挥作用。而且微生物与微生物之间还存在着互生、共生和对抗的关系,所以,最好不要同时使用多种有益菌肥。
另外,要注意需要不断补充新的菌肥,比如基肥用过后,可多次追同一种生物菌肥,以壮大菌群,增强它的作用。

3.选择微生物菌肥一定要根据作物来选择。
(1)对于大田作物,像水稻、王米、小麦等,建议选择复合微生物肥。
因为复合微生物肥料中既包含了菌、又包含氮、磷、钾养分以及有机质,使用起来更方便。
在单独使用氮肥、磷肥或钾肥的地块,可以配合施用微生物菌剂,起到促生长、抗病抗虫等作用。
(2)对于瓜果蔬菜等经济作物,建议使用生物有机肥或微生物菌剂。
既可以改良土壤,减轻作物病害,增强作物抗性,还能改善瓜果蔬菜的口感和品质。
03
山东唐氏化工“幸运豆”豆粕菌肥,你用了吗?

益生菌腐熟大豆蛋白,非转基因大豆为基础原料,深层液体发酵的技术,有益活菌数≥5.0亿/克、
上一篇:亚磷酸钾为啥能成为肥料新宠?
下一篇:大棚歇茬期,应该忙些啥?
- 铵态氮、硝态氮、酰胺态氮的区别及特点2024-10-11
- 苹果摘袋五忌,千万要注意!2024-10-11
- 抓好葡萄秋管,实现连年高产2024-10-11
- 有机肥是不是有机质含量越高越好?2024-05-29
- 矿源颗粒黄腐酸钾,你得这么用2024-05-29



